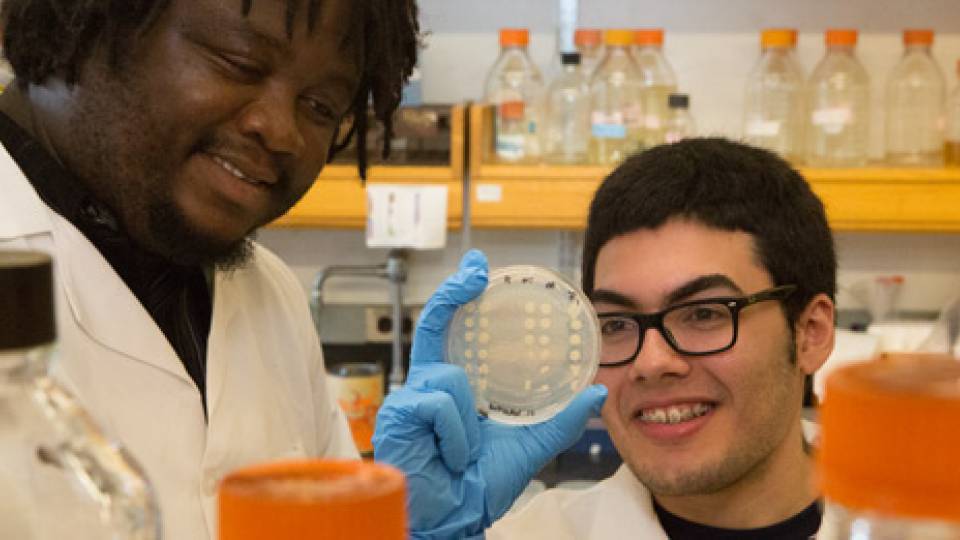
Lab Learning homepage visual

Several new research projects that promise to expand the bounds of knowledge have been selected to receive funding through Princeton's Office of the Dean for Research.
The Dean for Research Innovation Funds are awarded annually to promising and forward-looking research across various subject areas and disciplines. This year's funded projects range from open-ended studies in the natural and social sciences to targeted questions in cancer research, communications technology and sustainability. The projects are chosen by faculty-led committees based on the quality, originality and potential impact of the research.
"These funds represent Princeton University's commitment to support research that pushes boundaries in new directions," said Dean for Research Pablo Debenedetti, the Class of 1950 Professor in Engineering and Applied Science and professor of chemical and biological engineering. "Through these funds, Princeton researchers can take that extra risk or explore that new path that they might otherwise not have taken."
This year's Innovation Funds were awarded in four categories: natural sciences, social sciences, collaborations with industry, and the campus as a laboratory.
Innovation Fund for New Ideas in the Natural Sciences
This initiative supports the exploration of new concepts and ideas that are at an early stage and may not be ready for forming the basis of a competitive proposal submitted to a funding agency.
Putting light to work for advanced technologies
Just as electrons flowing within semiconductor chips form the basis of today's computing, the flow of light in materials known as photonic solids could dramatically improve our technological capabilities. These new materials can steer, trap and manipulate light in various directions on a chip, putting light to work in a variety of applications, from computing to sensors to telecommunications.
Salvatore Torquato, professor of chemistry and the Princeton Institute for the Science and Technology of Materials, and Paul Steinhardt, the Albert Einstein Professor in Science and professor of physics, made a breakthrough discovery a few years ago when they created new light-controlling structures known as two-dimensional hyperuniform disordered photonic solids. With this new funding, the team will extend this concept to three-dimensional solids, which are essential if the technology is to find widespread application. The research involves using computer algorithms to find the optimal hyperuniform disordered structures capable of directing light through the solids.
A new look at an established cancer drug
New research on how the anti-cancer drug cisplatin behaves in the body aims to improve drug efficacy while reducing side effects. Long a standard treatment for cancer, cisplatin and other platinum-based compounds kill tumors by modifying the cancer cells' DNA. But the drug also affects RNA, the close cousin of DNA that acts as messenger in the expression of genes into proteins.
Ralph Kleiner, assistant professor of chemistry, and his team will examine platinum-modified RNA in living cells, a step that first involves the creation of fluorescent tags that make the structures visible under the microscope. The team will attempt to answer questions about how the drug's effects on RNA contribute to its anti-cancer activity, drug resistance and side effects. The ultimate goal is to provide new directions for research on the role of RNA in diseases and treatments.
Exploring the role of the microbiome in antibiotic resistance
A new theory to explain the pervasiveness of antibiotic drug resistance puts some of the blame on our own microbiome, the trillions of bacterial cells that live in the human intestines. These normally harmless bacterial cells may act as a reservoirs where genes that cause antibiotic resistance can survive and spread.
Mohamed Abou Donia, assistant professor of molecular biology, will investigate whether antibiotic-resistance genes can transfer from our microbiome bacteria into disease-causing bacteria that are passing through the intestines and are then excreted and able to infect new individuals. The researchers will also look into the source of these antibiotic resistance genes, and whether they originated in the microbiome or have been transferred from passing bacteria. To carry out these investigations, the team will develop novel computational algorithms to first sift through all known antibiotic-resistance genes and identify ones that are found in human microbiome samples. Then, through mouse experiments, they will explore the effects that these genes have on the spread of antibiotic resistance.
Innovation Fund for New Ideas in the Social Sciences
This fund encourages innovation and scholarship on enduring questions through the development of new ideas, working groups, conferences, technologies or other scholarly work.
Workshop on historical systemic collapse
Today's increasingly interdependent systems — of agriculture, hydrology, electricity, finance, epidemiology, infrastructure and other facets of civilization — elevate the risk that a failure in one area could lead to systemic failure in multiple areas. The goal of this project is to study historical collapses to gain insights that can be applied to the goal of preventing future catastrophic outcomes.
Although historical failures may lack the level of global integration of today's systems, many of the elements are the same, according to project leader Miguel Centeno, the Musgrave Professor of Sociology and professor of sociology and international affairs. Centeno and colleagues in the Woodrow Wilson School for International and Public Affairs will convene two workshops to bring together historians and social scientists from within the University and from around the world to discuss systemic collapse on ecological and social levels.
Through a glass darkly: Depicting alchemical change from 1400 to 1700
This project aims to bring together historians of science and art to explore the craft of alchemy and its practitioners in early modern Europe. Alchemical imagery is rich with fantastical green lions, red toads and other objects. These images provide the starting point for exploring how alchemists sought to understand the nature of chemical transformations — what we now call “reactions.” Alchemists went beyond simple mechanistic explanations to encompass theological and medical debates about the relationship between body and soul, visible and invisible, and other profound questions.
Through this project, Jennifer Rampling, assistant professor of history, seeks to connect the history of alchemy to broader intellectual and cultural conceptions of change in early modern Europe, by bringing together evidence from alchemical images, texts, archaeological evidence and experimental reconstructions conducted in laboratories. The result will be a monograph, a conference and an exhibition aimed at bringing to a wider audience the early modern struggle to master the outward properties of matter and its inner mysteries.
Innovation Fund for Industrial Collaborations
This fund supports collaborations between Princeton researchers and external companies with the goal of fostering basic research that eventually may become available to the public as products, technologies or services. The award requires the pledge of a matching contribution from the company in the second year of the project.
Collaboration targets virulent acne
Acne is normally an irritating but fleeting affliction, but it can turn virulent and leave lasting scars. Mohammad Seyedsayamdost, assistant professor of chemistry, will team with scientists from Johnson & Johnson to explore new ways to understand and treat virulent acne. The Princeton researchers will search for factors that may turn on genes that drive this behavior. The Seyedsayamdost lab has developed special methods for activating and studying genes that are usually inactive, or "silent." Using these methods, the team will study the regulatory pathways that contribute to virulence.
Innovation Fund for the Campus as a Lab: Faculty Research in Sustainability, Energy and the Environment
The use of Princeton's campus as a research laboratory is the focus of this fund, which aims to advance knowledge and practice in areas of sustainability, energy and the environment. Several of the projects involve undergraduate researchers teaming with faculty members and graduate students to conduct the projects. This initiative is made possible by support from the Office of the Dean for Research, the Andlinger Center for Energy and the Environment, the High Meadows Foundation Sustainability Fund, the Princeton Environmental Institute, the Office of the Dean of the College, and Facilities.
Technological innovations to mitigate exposure to air pollution
To better inform the public and campus community about regional air quality, this project will deliver local, up-to-the-minute air quality information via a cellphone app. The research, led by Elie Bou-Zeid and Mark Zondlo, associate professors of civil and environmental engineering, takes advantage of the University's location in the heavily populated and industrialized greater New York region.
The problem the technology addresses is that while air quality data are available online from various government agencies, the data are regional rather than local, and users find them difficult to access. Bou-Zeid and Zondlo's project will combine two advanced pollution-sensing systems to provide readings of local air quality, allowing users to see how pollution is affected by proximity to main roads and how pollutant concentrations vary by time of day. By accessing these data via a cellphone app, individuals can incorporate air quality into their daily decisions.
Consumer-driven methods to reduce demand for unsustainably grown palm oil
The widely used ingredient palm oil has potentially negative environmental and health impacts. The demand for the oil has led tropical forests to be replaced with palm plantations, and the oil is high in saturated fat. A collaboration between David Wilcove, professor of ecology and evolutionary biology and public affairs and the Princeton Environmental Institute, and Smitha Haneef, assistant vice president, University Services, will include undergraduate researchers who will work with Princeton's residential dining halls as laboratories to explore options for reducing use of unsustainably grown palm oil.
One goal of the project is to encourage the use of palm oils certified by the Roundtable on Sustainable Palm Oil, which promotes better environmental practices. Another goal is to examine options for replacing existing products used by the dining halls with palm oil-free alternatives. The project will also raise awareness among students about the concerns with palm oil and suggest strategies for reducing environmental harm while improving student health.
Comparing the yield and nutritional content of vegetables grown on the Princeton campus
The need for healthy, locally produced vegetables in urban areas has increased the popularity of vertical farming, where crops are grown indoors under artificial lights and fed liquid nutrients. A new project led by Stephen Pacala, the Frederick D. Petrie Professor in Ecology and Evolutionary Biology, and Paul Gauthier, associate research scholar in the Department of Geosciences, will assess the nutritional content of vertically farmed vegetables and compare them to organically grown vegetables.
The researchers will use various methods in the lab to detect amino acids, nutrients, proteins and vitamins. The research team, which will involve undergraduates, will build on existing efforts by eating clubs, student groups and the colleges to study vegetables produced on campus and to share the results of these studies with the campus community.
Campus All-Renewable Transportation (CART)
Solar-powered campus vehicles could reduce the University's demand for electricity while meeting needs for transportation on short, routine trips. A team led by Forrest Meggers, assistant professor of architecture and the Andlinger Center for Energy and the Environment, plans to update an existing electric golf cart with a solar panel and a battery similar to those used in hybrid electric cars.
The idea to build the cart arose from an analysis conducted by undergraduates in a course taught by Meggers called “Designing Sustainable Systems” (ENE 202). Students evaluated electric golf cart usage on campus and determined that solar power could replace electricity given Princeton's geographical location and weather. Through this project, undergraduate researchers will build a solar-powered cart and explore its feasibility for providing clean-energy transportation for campus alumni weekends and for everyday use.
SMART Sensing for more efficient and comfortable campus buildings
Campus buildings require tremendous amounts of energy for heating and cooling, yet most buildings lack efficient ways to measure the comfort level of occupants. The temperature of a room typically accounts for only 50 percent of the occupant's comfort. A major unaddressed source of comfort comes from the temperature of nearby surfaces, such as walls and windows.
The aim of this project is to use a new technology developed by Forrest Meggers and his team called the SMART sensor to detect these so-called radiant sources of heating and cooling. The project will examine the campus to optimize radiant heating and cooling systems that are already in place, and develop new systems and strategies. The team will include partners in Princeton's Facilities organization.